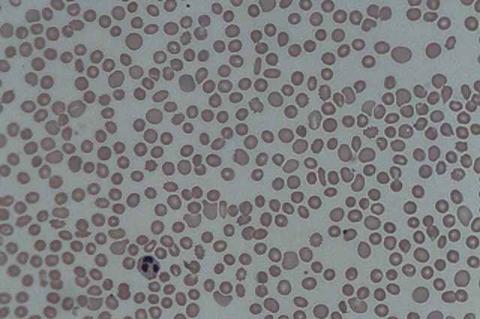
Thrombocytopenia_1

Houston Methodist Research Institute is collaborating with the Coalition for Epidemic Preparedness Innovations (CEPI) and leading scientific institutions in the Republic of Korea to develop what could become the world’s first mRNA vaccine against severe fever with thrombocytopenia syndrome (SFTS)—a tick-borne viral disease associated with this condition.
Symptoms typically emerge after people are bitten by infected ticks or possibly infected domestic animals such as cats. They may range from fever and vomiting to multi-organ failure and death, especially in older adults. Severe SFTS cases have been reported in China, Japan, Korea, Taiwan and Vietnam.
Jimmy Gollihar, Ph.D., chief of translational sciences and head of Antibody Discovery and Accelerated Protein Therapeutics at Houston Methodist Research Institute, said Houston Methodist will apply cutting-edge AI and computational techniques to accelerate vaccine design—reducing timelines from weeks or months to hours while ensuring safety and broad immune protection.
“We are applying advanced AI and computational immunology to dramatically shorten the time it takes to move from a viral genome to a rationally designed vaccine candidate,” Gollihar said. “By working hand-in-hand with our partners in Korea and CEPI on this SFTS ‘prototype’ vaccine, we aim to design components that are both safer and capable of eliciting broad, durable protection, while generating insights that can be rapidly transferred to other phenuiviruses.”
Family of viruses
Phenuiviruses are a large and diverse family of viruses that infect plants and animals—including humans and livestock. They are commonly transmitted by arthropod vectors, which are invertebrates with segmented bodies and jointed limbs, such as ticks and mosquitoes.
The collaboration aligns with the 100 Days Mission—a global goal, spearheaded by CEPI, prepping the world to respond in as little as 100 days when the next pandemic threat emerges.
“We don’t know what the next pandemic will be, but we know that we need to be prepared,” CEPI CEO Dr. Richard Hatchett said. “By advancing an SFTS vaccine, we will both help to address an increasingly menacing viral threat in Asia and generate scientific knowledge that could dramatically accelerate our response to the next Disease X. That way, we won’t be wasting valuable time creating a new vaccine from scratch if a deadly new phenuivirus emerges in the future.”
Other collaborators in the project include the International Vaccine Institute (IVI), ST Pharm, Seoul National University and the Korea Disease Control Agency. CEPI will invest up to $16 million to support preclinical and Phase I/II trials in Korea, led by IVI.
Topics
- Asia & Oceania
- Coalition for Epidemic Preparedness Innovations
- Healthy Land
- Houston Methodist Research Institute
- Immunology
- Infection Prevention & Control
- Infectious Disease
- International Vaccine Institute
- Japan
- Jimmy Gollihar
- Korea Disease Control Agency
- mRNA vaccines
- One Health
- phenuiviruses
- Seoul National University
- severe fever with thrombocytopenia syndrome
- ST Pharm
- USA & Canada
- Vaccinology
- Veterinary Medicine & Zoonoses
- Viruses
No comments yet